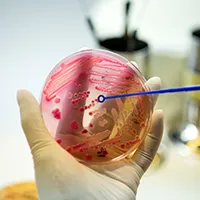
Solution Image

We believe in results you can see and trust. Our AI technology is delivering faster diagnoses, improving patient care, and optimizing clinical efficiency—backed by real data from hospitals around the world.
AI predicts faster, supporting global diagnoses.
Repetitive clinical tasks are handled efficiently by AI.
AI processes data to enhance outcomes.
Average cost saving per hospital.
Ensuring uninterrupted patient safety and remote care insights.
We bring together medical expertise, data science, and cutting-edge AI to deliver faster, safer, and smarter healthcare solutions. We start by understanding your unique needs, challenges, and goals, ensuring every solution we design is tailored to your healthcare environment.
Transforming healthcare with intelligent, scalable, and real-time AI technologies tailored to improve clinical accuracy, operational efficiency, and patient care outcomes.
Deliver accurate, real-time diagnosis with AI models trained on vast clinical datasets for radiology, pathology, and more.
Diseases
Diagnostic accuracy

ROI

Identify high-risk patients early and forecast outcomes using machine learning algorithms.




Join the future of patient-centered care. Connect with our team to discover how our AI innovations can revolutionize your healthcare operations.